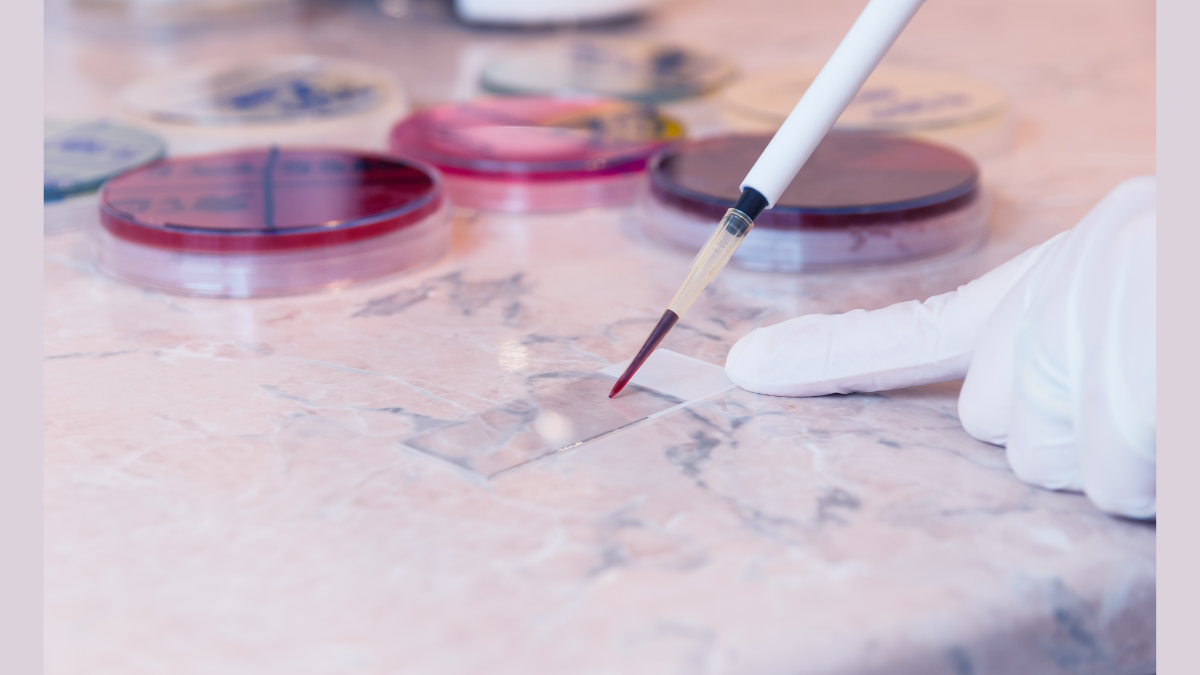

A natural compound could help fight aggressive leukaemia and amplify the effect of chemotherapy drugs
Forskolin, a natural compound derived from a plant, could significantly improve treatment outcomes for an aggressive form of leukaemia, known as KMT2A-rearranged Acute Myeloid Leukaemia (KMT2A-r AML), according to a new study from the University of Surrey.
The study, published in the British Journal of Pharmacology, shows that not only does forskolin directly stop the growth of leukaemia cells, but it also enhances the effectiveness of chemotherapy drugs. Researchers from Surrey found that forskolin activates Protein Phosphatase 2A (PP2A) and stops the expression of several cancer-promoting genes (MYC, HOXA9 and HOXA10).
The research also shows a significant and unexpected finding, as forskolin was found to substantially increase the sensitivity of KMT2A-r AML cells to daunorubicin, a standard-of-care chemotherapy drug. This effect, however, was not dependent on PP2A activation: forskolin appeared to block P-glycoprotein 1, which allows cancer cells to pump chemotherapy drugs out, leading to drug resistance. By blocking P-glycoprotein 1, forskolin allowed for more daunorubicin to go inside the leukaemia cells, making the chemotherapy much more potent.
We are committed to funding innovative research and are proud to have supported Dr Esposito’s work. AML is one of the most aggressive and deadly cancer types, and this study not only deepens our understanding of KMT2A-rearranged AML but also opens the door to kinder, more effective treatments. Work like this is essential if we are to achieve our goal of doubling the five-year survival rate for AML within the next decade.Dr Simon Ridley, Director of Research and Advocacy at Leukaemia UK
The study, funded by Leukaemia UK, was a collaborative effort between researchers at the University of Surrey, University of Roehampton, Barts Cancer Institute-Queen Mary University of London, Great Ormond Street Institute of Child Health London- UCL and the Genomic Regulation, CRG Barcelona (Spain).
Related sustainable development goals
Media Contacts
External Communications and PR team
Phone: +44 (0)1483 684380 / 688914 / 684378
Email: mediarelations@surrey.ac.uk
Out of hours: +44 (0)7773 479911